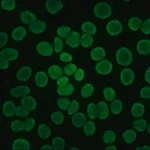
Merck ANTI-HUMAN IGG (FAB SPECIFIC) FITC &

Merck MOUSE MONOCLONAL ANTI-FITC (CLONE FL-D6)
✨AI 추천 연관 상품
AI가 분석한 이 상품과 연관된 추천 상품들을 확인해보세요
연관 상품을 찾고 있습니다...
| Size (크기) | 1/ML |
| Packaging UOM (포장 단위) | ML |
| Number Of Containers Package Unit (포장 단위당 제품 수) | .2ML/ML |
| Individual Container Size In Package Unit (개별 포장당 용량) | 1/ML |
| UNSPSC (UNSPSC 분류) | 12352203 |
| Flash Point (발화점) | Not applicable |
| Storage (보관온도) | -20C |
| Merck URL (머크 페이지 주소) | https://www.sigmaaldrich.com/US/en/product/SIGMA/F5636?context=product |
| F5636-.2ML 제품설명 |
MOUSE MONOCLONAL ANTI-FITC (CLONE FL-D6) MOUSE MONOCLONAL ANTI-FITC (CLONE FL-D6) |
배송/결제/교환/반품 안내
배송 정보
| 기본 배송비 |
| 교환/반품 배송비 |
|
|---|---|---|---|
| 착불 배송비 |
| ||
| 교환/반품 배송비 |
| ||
결제 및 환불 안내
| 결제수단 |
|
|---|---|
| 취소 |
|
| 반품 |
|
| 환급 |
|
교환 및 반품 접수
| 교환 및 반품 접수 기한 |
|
|---|---|
| 교환 및 반품 접수가 가능한 경우 |
|
| 교환 및 반품 접수가 불가능한 경우 |
|
교환 및 반품 신청
| 교환 절차 |
|
|---|---|
| 반품 절차 |
|
문의 0
로그인 후 문의를 할 수 있습니다.